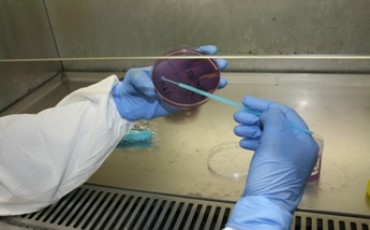

Menzies’ postdoctoral research fellow, Dr Steve Tong, was recently awarded a competitive grant and a fellowship as part of the National Health and Medical Research Council’s (NHMRC) yearly multi-million dollar funding round. His $1.06 million dollar project grant is titled: A novel Hepatitis B virus genotype in Indigenous Australians: impact on vaccine efficacy and clinical outcomes, and is a joint collaboration with the Victorian Infectious Diseases Reference Laboratory (VIDRL).The project was started with Steve's colleagues, Joshua Davis (Menzies) and Stephen Locarnini (VIDRL). Steve shared his thoughts on the new funding.
What major health issue does your research hope to address and how?
Infection with Hepatitis B virus (HBV) can lead to liver failure and liver cancer and ultimately death. In Northern Australia, up to 20 per cent of Indigenous Australians living in remote communities are infected with HBV.
Currently, a vaccine is administered to Indigenous infants to try to prevent HBV infection, but recent research suggests it may not be as effective as first thought. We also know that HBV is still causing high rates of liver cancer in Indigenous populations.
Based on the genetic DNA fingerprint of each HBV from individual patients, the HBVs can be grouped into different ‘genotypes’. Through this process we have recently identified a novel HBV genotype known as HBV/C4 circulating in Northern Territory (NT) Indigenous communities. This HBV/C4 virus is different from the HBV used in the current vaccine given to all Australian children (including Indigenous children). Therefore, the immune response generated by the vaccine may not protect as well against infection by HBV/C4.
Our project will determine if HBV/C4 is linked to poor vaccine responses and accelerated liver disease. This could lead to changes in our HBV vaccine strategy and clinical management of HBV/C4 infections and ultimately prevent HBV infections and severe consequences of infection.
What is the most exciting aspect of your funding win?
This project was started with my colleagues Joshua Davis and Stephen Locarnini during coffee discussions. No-one had previously looked at the kind of Hepatitis B virus (HBV) that infects Indigenous Australians (despite Hepatitis B first being discovered in an Indigenous Australian). Through talking to Indigenous patients we saw in our clinics and obtaining samples from them and then DNA sequencing the virus, we discovered a novel genotype of HBV in every single Indigenous patient. This virus looks different to the virus that is used in the current vaccine. It is extremely exciting to now be able to investigate the public health importance of our initial findings – it is crucial to find out if the current Hepatitis B vaccine works as well as it should in Indigenous populations.
What are the proposed details of your research methodology?
We will:
- Determine the prevalence of Hepatitis B infections in three vaccinated cohorts from the Top End (children of HBV infected mothers, a community-wide sample, and the longitudinal Aboriginal Birth Cohort)
- Establish longitudinal cohorts of chronic and occult infections from the above participants to see how frequently complications such as liver cancer occur in patients infected with the novel HBV/C4 virus
- Apply cutting-edge virological laboratory assays to all the samples collected in the above to determine if antibodies elicited by the vaccine work against the HBV/C4 virus
- Determine if HBV/C4 is more likely to generate cancerous changes in liver cells compared to other HBV genotypes.
What are the broader health implications of your grant?
Our results will inform future vaccine strategies (e.g. new vaccine or changed schedule) and lead to evidence-based approaches to the management and treatment of HBV/C4 infections (both chronic and occult) in Indigenous Australians (e.g. earlier liver cancer screening; earlier antiviral treatment). Our aims are to reduce both the rates of HBV infection and complications for those already infected.
What are the timeframes for your project and any other major milestone dates?
We hope to complete the project over a three year period. We will initially start with finding participants who are at risk of having a Hepatitis B infection, then determining whether they do indeed have the HBV/C4 genotype, and then following these patients over time. The laboratory viral studies will be conducted as the samples are obtained.
For more information, please click here.